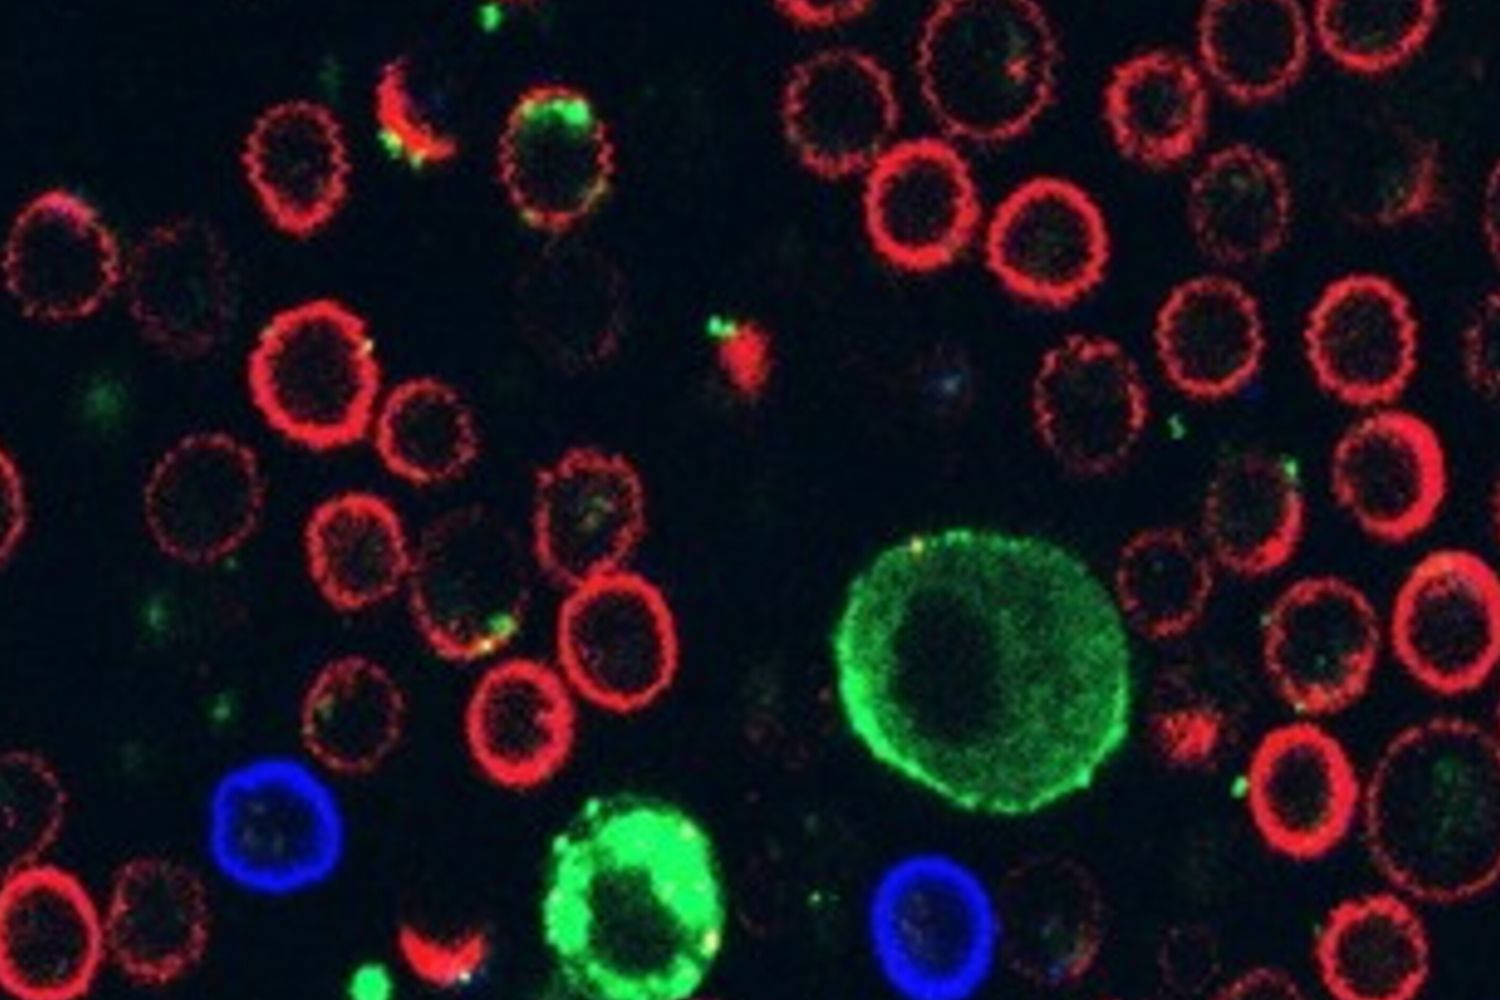
Melanoma, scoperto come paralizza i linfociti T

Melanoma, scoperto come paralizza i linfociti T

AGI - Le cellule di melanoma sono in grado di paralizzare le cellule del sistema immunitario deputate alla loro eliminazione attraverso il rilascio di vescicole extracellulari, minuscole strutture membranose che interferiscono direttamente con l’attività dei linfociti T. È quanto emerge da uno studio internazionale coordinato dalla Tel Aviv University e pubblicato sulla rivista Cell.
La ricerca, guidata da Carmit Levy, ha analizzato il comportamento delle cellule tumorali del melanoma nelle prime fasi di sviluppo e durante l’interazione con il sistema immunitario. I dati indicano che le cellule cancerose secernono vescicole extracellulari contenenti molecole capaci di legarsi in modo selettivo ai recettori presenti sui linfociti T CD8, compromettendone la funzione citotossica o inducendone la morte.
Gli autori spiegano che queste vescicole, già note per il loro ruolo nella preparazione di un microambiente favorevole alla diffusione tumorale, agiscono anche come strumento di evasione immunitaria. In particolare, il legame tra i ligandi presenti sulla superficie delle vescicole e i recettori dei linfociti impedisce alle cellule immunitarie di riconoscere e attaccare efficacemente il tumore.
Il melanoma rappresenta la forma più aggressiva di tumore cutaneo e, nelle fasi avanzate, è caratterizzato da un’elevata capacità di metastatizzazione. Comprendere i meccanismi con cui il tumore elude la sorveglianza immunitaria è considerato un passaggio chiave per migliorare l’efficacia delle immunoterapie attualmente disponibili.
Secondo i ricercatori, la scoperta potrebbe in prospettiva contribuire allo sviluppo di nuove strategie terapeutiche mirate a bloccare l’interazione tra le vescicole extracellulari e le cellule immunitarie o a rafforzare la resistenza dei linfociti all’azione del tumore. Gli autori sottolineano tuttavia che saranno necessari ulteriori studi sperimentali e clinici per valutare la trasferibilità di questi risultati in ambito terapeutico.